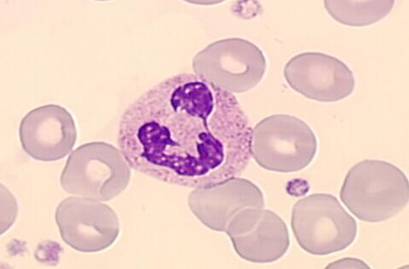
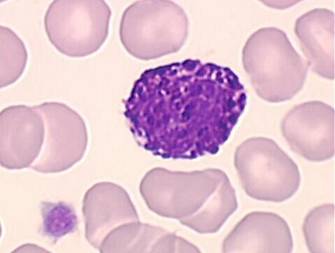
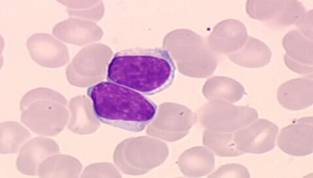

| CATEGORII DOCUMENTE |
| Alimentatie nutritie | Asistenta sociala | Cosmetica frumusete | Logopedie | Retete culinare | Sport |
LEUCOCITELE
- sunt in numar de 6-8 mii/mm3
-se impart in
- mononucleare (monocite 5% si limfocite 27%) si
polinucleare sau granulocite ( neutrofile 60-70%, eozinofile1-3%,bazofile0,5-1%).
-numarul lor creste : spre seara,in perioada de graviditate, efort fizic, boli infectioase.
-membrana leucocitara este foarte plastica si poate forma prelungiri citoplasmatice (pseudopode) cu roluri multiple.
-leucocitele inglobeaza corpi straini prin fagocitoza
-parasesc torentul sangvin prin diapedeza indreptandu-se spre agentii nocivi care au patruns in organism (chimiotaxie pozitiva)


Leucocitele se sintetizeaza in tesutul limfoid si
in maduva osoasa. Prezinta numeroase functii:
1)mobilitate;
2)marginatie;
3)diapedeza;
4)fagocitoza;
5)imunitara;
Cele mai active leucocite(viteza mare de deplasare 3mm/ora)sunt polimorfonuclearele neutrofile ( PMN )

Neutrofilele au rol in fagocitoza agentilor patogeni. Datorita vitezei de diapedeza si deplasarii rapide prin pseudopode , PMN-urile nu stau in sange mai mult de cateva ore. Ele ajung primele la locul infectiei , unde fagociteaza microbii, distrugandu-i. Numarul lor creste mult in infectii acute
Iesirea leucocitelor din vas este favorizata de incetinirea curgerii la nivelul focarului inflamator ( datorita vasodilatatiei ), precum si alipirii acestora de endoteliul capilar, fenomen denumit marginatie.
Marginatia, diapedeza si deplasarea prin pseudopode a leucocitelor spre focarul inflamator sunt favorizate de atractia leucocitelor de catre unele substante locale fenomen cunoscut sub denumirea de chimotactism pozitiv. Ajunse in apropierea microbilor , neutrofilele emit pseudopode si cu ajutorul lor ii inglobeaza , formand vacuole citoplasmatice, numite fagozomi.
Ulterior, lizozomii neutrofilelor se contopesc cu fagozomul.
In interiorul fago-lizozomului, microbul este digerat sub actiunea enzimelor lizozomale. Cand leucocitele fagociteaza un numar prea mare de microbi, ele sufera efectele toxice ale unor substante eliberate din acestia si mor.
Amestecul de microbi, leucocite moarte si lichid exudat din vase formeaza puroiul.
Eozinofilele sunt crescute in afectiunile alergice sau in parazitozele intestinale. Au rol in reactiile alergice. Granulatiile lor contin histamina


Bazofilele au rol in coagularea sangelui, prin intermediul unei substante numita heparina , continuta in granulatii. Tot datorita heparinei, leucocitele bazofile au rol in metabolismul lipidelor,heparina favorizand dizolvarea chilomicronilor si dispersia lor in particule fine ce pot fi mai usor utilizate de catre tesuturi

Limfocitele au rol in reparare putandu-se transforma in celule conjunctive(fibrocite).Sunt crescute in infectiile cronice-TBC si sifilis.

Exista 3 tipuri de limfocite:
-T (originea in timus) care dau
imunitatea celulara;
-B (origine
in maduva osoasa) si dau imunitate umorala, mediata prin anticorpi;
-nonT,
nonB[ killer(K) si nonkiller(NK)]
Apelativul T sau B provine de la organele limfoide centrale in care se petrece " instructajul diferentiat al limfocitelor : timusul ( T ) si bursa limfatica ( B).
Toate limfocitele se dezvolta dintr-o celula cap de serie mica, celula stem unipotenta limfopoetica. Dupa formare, o parte din limfocite se fixeaza in timus, altele in maduva hematogena ( organ omolog cu bursa limfatica prezenta la embrionul de pasari ). Aici are loc un proces de diferentiere si specializare a limfocitelor.
In timus, se vor forma limfocitele T , capabile sa lupte direct cu antigenele, iar in maduva osoasa se vor forma limfocitele B, capabile sa lupte indirect cu antigenele prin secretia de anticorpi specifici.
Dupa nastere, limfocitele T si B migreaza din organele limfoide centrale in ganglionii limfatici unde vor genera limfocitele necesare apararii specifice a organismului.


Monocitele inglobeaza elemente de dimensiuni mari si formeaza tesut de granulatie si cicatriceal.


Monocitele sunt leucocite capabile de fagocitoza atat direct, cat si in urma
transformarii lor in macrofage, proces care are loc dupa iesirea monocitelor
din vase in tesuturi.
Monocitele si macrofagele
formeaza un singur sistem celular care fagociteaza atat microbii cat si, mai
ales, resturile celulare
( leucocite, hematii )si prin aceasta contribuie la curatirea si vindecarea
focarului inflamator.
Limfocitele au rol considerabil
in reactia de aparare specifica
Reglarea leucopoezei
- se face prin mecanisme neuroumorale complexe
- centrii leucopoiezei sunt situati in hipotalamus
- activitatea acestor centri se intensifica atunci cand in sange creste concentratia acizilor nucleici rezultati din distrugerea leucocitelor batrane.
- in cazul patrunderii in organism a unor agenti patogeni, are loc de asemenea o stimulare prin antigene a leucopoiezei , urmata de cresterea peste normal a leucocitelor, fenomen denumit leucocitoza.
- leucopoieza medulara se poate intensifica atat sub influenta stimulilor nervosi plecati de la centrii de reglare cat si a unor substante chimice numite leucopoietine.
- cresterea numarului de leucocite circulante poate avea loc si fara o crestere prealabila a leucopoiezei, numai prin mobilizarea rezervorului medular de leucocite. Acest mecanism asigura un raspuns precoce al organismului fata de invazia agentilor straini.
IMUNITATEA
ALERGIA
Imunitatea -stare
de rezistenta a organismului fata de factori patogeni.
-confera organismului capacitatea sa reziste microorganismelor si toxinelor ce
au tendinta sa distruga tesuturile si organele.
Imunitatea innascuta -parte a imunitatii ce rezulta
din procese generale.
-include urmatoarele:
-fagocitarea de catre leucocite
si celulele sistemului de macrofage tisulare a bacteriilor
si a altor agenti patogeni
-distrugerea microorganismelor
patrunse in stomac de catre secretiile acide ale stomacului si de catre
enzimele digestive.
-rolul de bariera
antiinfectioasa a pielii.
-prezenta in sange a anumitor
compusi chimici, care se ataseaza de microorganismele straine sau toxine, care
sunt distruse.
Imunitatea castigata
-capacitatea org. de a dezvolta
mecanisme de aparare puternice impotriva unor bacterii inalt patogene,
virusuri, toxine, tesuturi straine de specie.
-acorda o protectie foarte mare(
imunitate fata de toxina botulinica,toxina tetanizanta obtinute prin
vaccinare).
Cele doua tipuri fundamentale ale imunitatii castigate
IMUNITATE UMORALA(imunit. cu celule B)
organismul produce anticorpi circulanti=molecule globulinice ce ataca
microorganismele patogene.
IMUNITATE MEDIATA CECULAR(imunit. cu celule T)
Formarea unui numar mare de limfocite activate, destinate sa distruga specific
ag. patogeni straini.
Antigenele
-imunitatea castigata apare dupa
ce organismul vine in contact cu microorganisme straine sau toxine
-fiecare toxina sau fiecare tip
de organism contine intotdeauna unul sau mai multi compusi chimici specifici in
structura lor, care sunt diferiti de toti ceilalti compusi; acestia sunt
proteine sau polizaharide mari si sunt cei care initiaza imunitatea castigata=ANTIGENE
-o substanta sa fie antigenica:
greutate moleculara mare; antigenitatea depinde de grupuri care se repeta
regulat pe suprafata moleculei mari si care se numesc EPITOPI.
Rolul limfocitelor in imunitatea castigata
-limfocitele sunt localizate in ggl.
limfatici, dar si in splina, reg. submucoasa a tractului intestinal si maduva
osoasa.
-tesutul limfoid din tractul
intestinal este imediat expus antigenelor ce patrund in intestin.
-tesutul limfoid din
naso-faringe(tonsilele si corpii adenoizi) intercepteaza Ag. ce patrund pe
calea tractului respirator.
-tesutul limfoid din ggl.
limfatici vine in contact cu Ag. ce patrund prin tesuturile periferice.
-tesutul limfoid al splinei si
maduvei osoase intercepteaza Ag. din sangele circulant.
LIMFOCITELE T si B
-aceste doua tipuri de limfocite
provin, la embrion, din celula stem hematopoetica pluripotenta, care se
diferentiaza si devine celula limfoida.
-ele sunt diferentiate mai
departe sau sunt preprocesate in urmatoarele moduri:
-unele sunt procesate in timus si
se numesc Ly.T-responsabile de imunitatea celulara
-unele sunt preprocesate in ficat
in perioada fetala si in maduva osoasa in perioada tarzie a vietii fetale si
dupa nastere-se numesc Ly.B-responsabile de imunitatea umorala.
Instruirea Ly.T si B
-rolul timusului in instruirea
Ly.T apare putin inainte de nastere si cateva luni dupa aceasta, de aceea
indepartarea timusului dupa aceasta perioada nu va afecta serios sistemul imun
al limfocitelor.
-hormonul timic creste
activitatea Ly.T si determina proliferarea acestora dupa ce au parasit timusul.
-instructajul Ly.B are loc in
mijlocul perioadei fetale in ficat si continua dupa nastere in maduva osoasa.
Rolul clonelor limfocitare
-cand in tesutul limfoid un Ag.
vine in contact cu Ly.B sau T,unele Ly.T se transforma in celule T, iar Ly.B
formeaza anticorpi.
-exista un numar egal, cel putin
cate un milion de tipuri diferite de Ly.B si T preformate care, atunci cand
sunt stimulate de un Ag. corespunzator devin capabile de a forma anticorpi si
cel.T
-cand limfocitul specific este
activat de Ag. sau, el se multiplica cu o rata mare formand un numar enorm de
Ly. identice.
-fiecare grupare de limfocite
capabile sa formeze celule de aparare sunt clone limfocitare.
Originea clonelor limfocitare
-genele formeaza molecule mari de
ARN ce contin multiple segmente functionale mici, fiecare din acestea
codificand anumite portiuni ale unui Ac. sau ale unei portiuni din markerul
celulei T
-moleculele de ARN sunt taiate de
unele enzime in segmente mai mici fiecare codificand segmente multiple de
anticorpi sau markeri celulari dand nastere la milioane de combinatii posibile.
SISTEMUL LIMFOCITELOR B-IMUNITATEA UMORALA SI ANTICORPII
-inainte de a fi expuse
antigenului specific, clonele de Ly.B se gasesc dormante in tesutul limfoid.
-Ag. strain va fi fagocitat de
macrofagele tisulare si prezentat apoi Ly.B
-Ag. Va fi prezentat si celulelor
T "helper" activate
-Ly.B se maresc si iau aspectul
de limfoblasti, unele se diferentiaza
in continuare si se transforma in plasmocite.
-celulele se divid cu o rata de
diviziune la 10 ore, timp de noua diviziuni dand nastere la o populatie de 500
de plsmocite in 4 zile.
-plasmocitele mature produc
anticorpi(gamaglobuline) cu o rata de 2000 molec./s pentru fiecare plasmocit.
FORMAREA CELULELOR CU MEMORIE-RASPUNS IMUN PRIMAR SI SECUNDAR
-unii limfoblasti nu vor forma
plasmocite ci Ly.B noi, astfel
populatia de clone creste foarte mult.
-din punct de vedere imunologic
ele raman dormante pana vor fi activate inca o data de o noua cantitate din
acelasi Ag. Sunt numite celule cu memorie.
-expunerea ulterioara la acelasi
Ag. determina un raspuns mult mai rapid si mai puternic raspuns secundar.
-vaccinarea explica acest
fenomen.
NATURA ANTICORPILOR
-Ac. sunt gamaglobuline compuse
din lanturi polipeptidice usoare (L-light) si grele(H-heavy), cate doua lanturi
din fiecare.
-un lant greu are in paralel un
lant usor la unul din capete reprezentand portiunea variabila.
-ceea ce ramane din fiecare lant
este portiunea constanta
-portiunea variabila este cea
specifica fiecaruia si se fixeaza de un tip particular de Ag.
-portiunea constanta determina
difuzibilitatea anticorpului in tesuturi, aderenta, usurinta cu care trec prin
membrane.
-fiecare Ac. este specific unui
tip particular de Ag.
-cand Ac. este foarte specific
exista mai multe situsuri de legare, cuplajul Ac.-Ag. devenind extrem de
puternic.
MECANISMUL DE ACTIUNE AL ANTICORPILOR
A. atacul direct al Ac. asupra Ag. strain:
1.aglutinare-sunt adunate
intr-un complex mai multe particule mari(bacterii, eritrocite)
2.precipitare-complexul
Ag.-Ac. este mare insolubil si va precipita(toxina tetanica)
3.neutralizare-acoperirea
locusurilor toxice ale Ag.
4.liza-atacarea directa a
membranelor Ag.
B. activarea sistemului complement.
-Complement=sistem de 20
proteine diferite(precursori enzimatici)
-actorii principali sunt 11
proteine notate cu C1 pana la C9,B si D.
-cand un Ac. se fixeaza de Ag. un locus reactiv specific din
portiunea constanta a Ac. se activeaza, se leaga direct de molecula C1,
declansandu-se cascada de reactii secventiale, C1 activand mai departe alte
enzime.
EFECTELE ACTIVARII CASCADEI COMPLEMENTULUI
-opsonizarea si fagocitoza-unul
din produsii cascadei C3b activeaza fagocitoza facuta de neutrofile si
macrofage
-liza-cel mai important produs al
cascadei este complexul litic ce rupe membranele bacteriene
-aglutinarea-aderarea
microorganismelor unul de celalalt.
-neutralizarea
virusurilor-virusurile isi pierd virulenta prin alterarea structurii.
-activarea mastocitelor si a
bazofilelor-fragmentele C3a, C4a si C5a au acest rol. Celulele activate
elibereaza histamina crescand fluxul sg. local, producand reactii tisulare
locale ce ajuta la imobilizarea Ag.
SISTEMUL LIMFOCITELOR T-IMUNITATEA CELULARA
-Ly.T raspund prin activare,
celulele activate trecand in circulatie ajungand in spatiile tisulare.
-celulele T cu memorie determina
un raspuns ulterior la acelasi Ag. mult mai rapid
-Ag. se leaga de molecule receptor de
pe suprafata cel.T.
-pe suprafata unei singure cel. T
exista cel putin 100.000 de situsuri receptoare.
-tipuri de cel.T- 1.cel. T
helper, 2. cel. T citotoxice, 3. cel. T supresoare
CELULELE T
1-cel. T helper
-cele mai numeroase(3/4), sunt
reglatoare a functiilor imune, rol indeplinit cu ajutorul
limfokinelor(mediatori proteici)
-rolurile lor: -stimularea cresterii si proliferarii cel.T
citotoxice si supresoare
-activarea macrofagelor in tot
organismul
2-cel. T citotoxice
-numite cel. Killer atacand
direct microorganismele dar si celule din propriul organism
-elibereaza perforine ce produc
orificii mari in membrana celulelor atacate, apoi elibereaza substante
citotoxice in interiorul celulei atacate. Pot ataca cel. canceroase, cel.
miocardice transplantate si orice cel. straina.
3-cel. T supresoare
-deprima functia cel.T citotoxice
si helper, se evita reactii imune excesive.
TOLERANTA SISTEMULUI IMUNITATII DOBANDITE FATA DE PROPRIILE TESUTURI
-mecanismul imun local recunoaste
propriile tesuturi
-sunt formati cativa Ac.
impotriva propriilor Ag.=TOLERANTA AUTOIMUNA
-fenomenul se creaza in timpul
instructajului Ly.T si Ly.B, toate clonele de limfocite specifice tesuturilor
proprii organismului distrugandu-se din cauza expunerii lor continue la
antigenele proprii.
-Autoimunitate=pierderea
tolerantei fata de propriile tesuturi
-bolile care apar in aceasta
situatie :
1.febra reumatica(dupa expunerea
la toxina streptococului, organismul face Ac. impotriva tes. din articulatii si
inima);
2.glomerulonefrita;
3.miastenia gravis(impotriva
receptorilor de acetilcolina=paralizie);
4.lupus eritematos
sistemic(imunizare impotriva mai multor tesuturi)
VACCINAREA
-determina imunitate castigata
-vaccinul contine microorganisme
moarte ce inca mai au Ag. chimici
-se face impotriva :febrei
tifoide, tusei convulsive, difteriei etc.
-imunitatea se poate obtine si
impotriva toxinelor, dar cu toxine tratate chimic ptr. a li se inlatura
toxicitatea:
tetanos, botulism
-se mai poate face prin
infectarea unei pers. cu un microorganism viu dar atenuat: poliomelita, febra
galbena, rujeola,
rubeola,
variola, etc.
ALERGIA(urticaria, febra fanului, astmul)
-se transmite genetic, prezenta
unei cantitati mari de anticorpi Ig.E=reagine
-are loc reactie alergen-reagina
-se pun in libertate mastocite si
bazofile atasate de Ig.E.
-substante eliberate:
1.histamina, 2.SRSA-subst. anafilactoida cu reactivitate lenta,amestec de
leucotriene, 3.subst. chemotactica ptr. eozinofile,ptr. neutrofile, 4.heparina
|
Politica de confidentialitate | Termeni si conditii de utilizare |
Vizualizari: 7849
Importanta: ![]()
Termeni si conditii de utilizare | Contact
© SCRIGROUP 2025 . All rights reserved